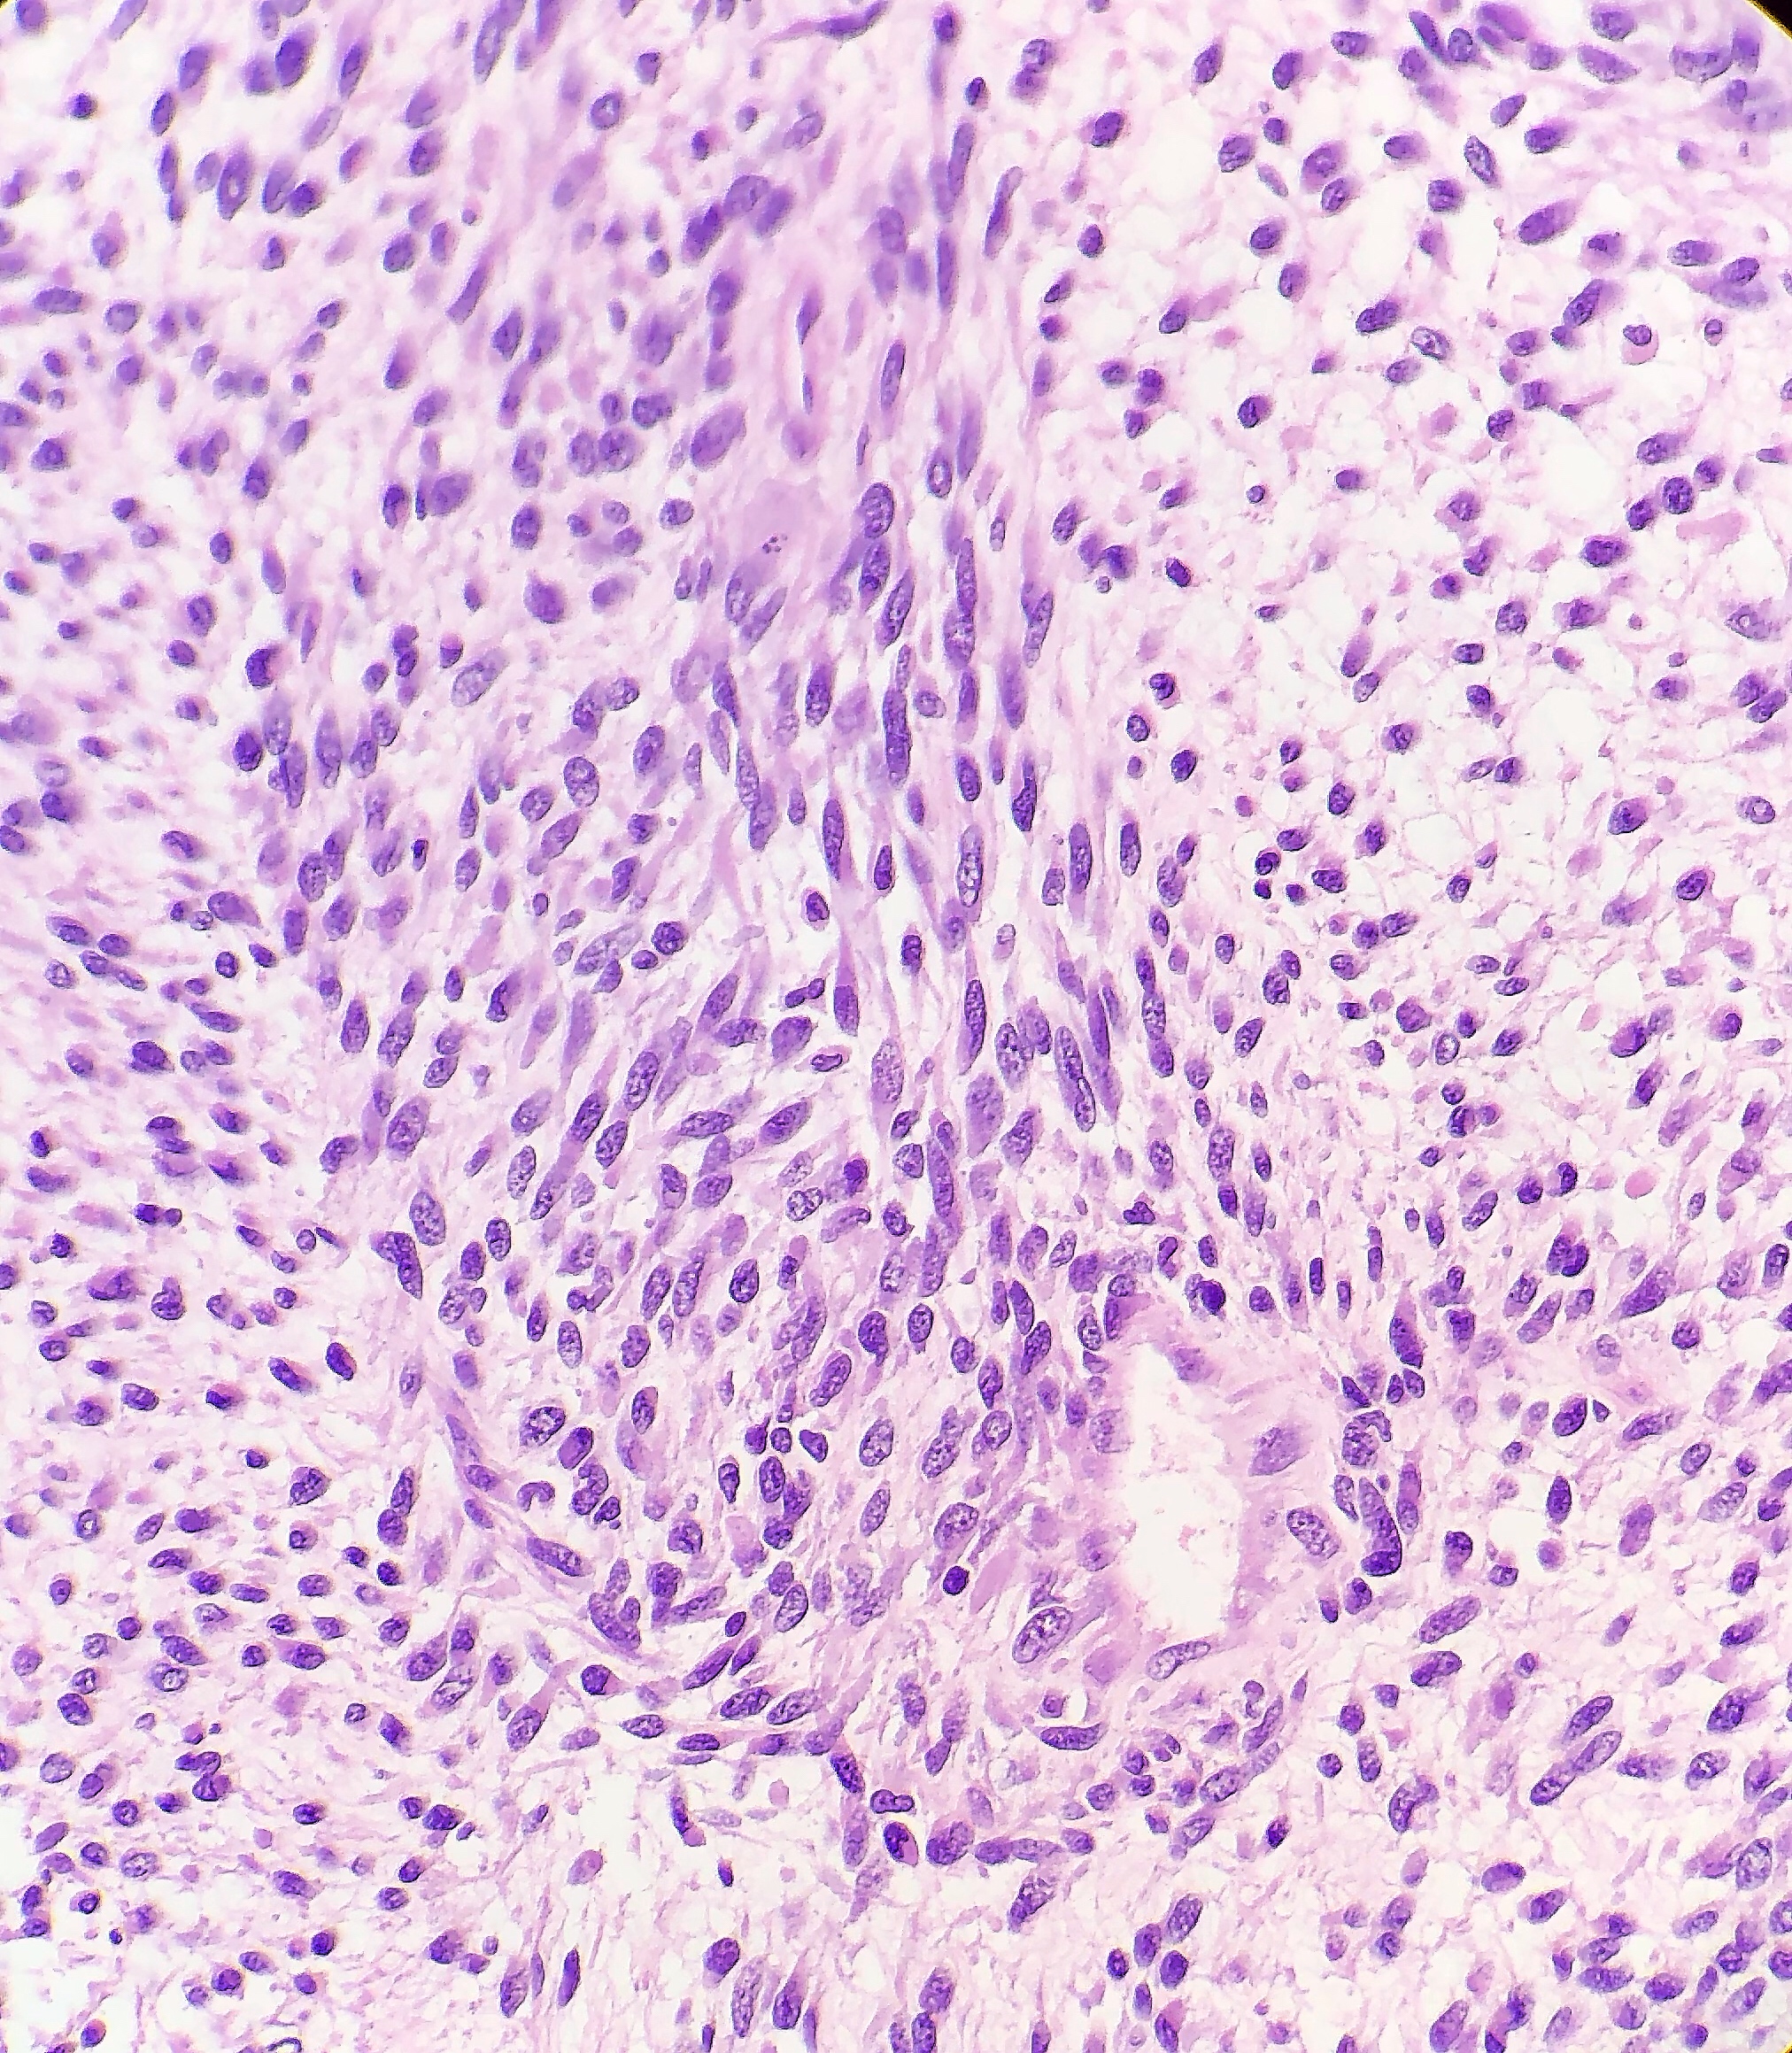

Hi again everyone!
Welcome back. Last month I talked about a colleague of mine, a fellow student who’s pursuing a career in pathology. The month before that I wrote a bit about Just Culture and how those of us in laboratory medicine ought to act as leaders for patient advocacy—especially when it comes to putting the needs of patients first. And in the spirit of progressing career timelines and fortuitous transitions, this month I want to talk about a place where Just Culture is tangible, where “patient come first” is a mission statement, and where I just spent the last month rotating in their Department of Laboratory Medicine and Pathology: The Mayo Clinic.

Before I go any further, if you haven’t seen the PBS Ken Burns’ documentary, I highly suggest you do; it’s fantastic. There are also a few excellent books on the hospital’s history and vision here and here. But back to the rotation: I can’t express how lucky I feel having spent time there or convey how much of a privilege it was to see pathology in a uniquely Mayo way. What I can do is try to talk a little bit about my experience and what that translates to regarding a culture of advocacy and collaboration; and I’ll share a case conference I presented on my last day in a topic I find fascinating.

Mission, Vision, and Values
As with any hospital, academic center, clinic, etc., you’re always going to have a driving philosophy that anchors the values of that particular institution. Some of my experiences in larger academic centers tout their strides at the forefront of medicine and translational research, others advertise that they treat the whole person body and spirit. Community hospitals sometimes lean into their integral part of, well, their communities as a center for trust and health. Sometimes institutions have specific populations to cater to or work intensely with industry and boast strong contributions to medical science. At the Mayo Clinic you’d be hard pressed to miss the message (in various forms) that “The Patients Come First”—in fact that line from many years ago comes from Dr. William Mayo delivering a commencement speech at a Rush Medical College graduation. (I was so happy to see so many Chicago-Mayo Clinic connections!)

It becomes very obvious that this culture of advocacy permeates into the daily proceedings there. The hospital makes a strong point to celebrate outreach, education, and research; and clinicians are given a cultivated environment in which to flex muscles of compassion for patient outcomes. It makes you a better clinician, and I argue, person. Everyone at this hospital has a voice and a seat at the table. I was continuously encouraged to interact with staff, clinicians, residents, fellows, and patients and contribute what I thought would benefit patient care. A unique perspective as a visiting medical student with previous MLS experience was both noted and celebrated.
Leadership in Pathology
In many of my pieces on this blog, I frequently discuss how we should champion active roles in testing stewardship, policy advocacy, and promoting positive patient outcomes. Granted, when you find yourself in larger, resource-rich, tertiary academic centers you can really push the envelope for progress. But generally, those of us on the ‘scopes operate in this margin between clinical medicine and translational research. Where does our leadership come in? What does it look like? I think it comes in the form of prolific contributions to societal guidelines and interdisciplinary work. Nowhere have I seen this more than my month in Rochester.
So many of their residents contributed abstracts and presentations at this year’s USCAP conference, some winning awards. The academic cycle of producing something great requires strong support from your home institution and that’s exactly what I saw. Not only were folks supported for their trips to conferences per usual, they were celebrated—hallway handshakes, accolades at morning conference, discussions post-meeting, and social media shares. Which, by the way, social media is now a leadership staple. You can’t go far in the present day without utilizing technology both inside and out of your practice. The Pathologist recently celebrated their first #TwitterPathAward for residents like Dr. Tiffany Graham at UAB for contributions to medical education and advocacy in pathology. Mayo clinicians, including residents, consultants, pathologist’s assistants, and more share case studies, educational material, and cutting-edge pathology news in terabytes! I now find myself increasingly active on social media representing pathology and interests within our field.

Side note: I’ve followed a number of these social media pages about cases in pathology for a while, and when I was fortunate enough to be part of ASCP’s Top 40 Under Forty 2017, I connected with lots of awesome laboratorians. Some of which I got to meet this month! Including a fellow blogger on this site, some celebrated path assistants, and a prolific parasite-discussing clinical microbiologist.
Case Conference
So, my presentation was intense! I’ve given plenty of case reports and conference discussions before, but this was an opportunity for me to explore quite a rare case in genetics and connect it with my interests in hematopathology. This was a case of a patient with Li-Fraumeni Syndrome (LFS) who developed therapy-related Acute Myeloid Leukemia. It’s not a current case and has since been signed-out and closed, but I’ll only be talking about the pathologic entities involved.

Essentially, this patient was found to have Li-Fraumeni after the second manifestation of an acute sarcoma—the first being osteosarcoma in her teenage years and the second breast cancer in her 30s. Both cancer diagnoses were treated accordingly, and this patient was going through routine work-up for anemia before being referred to the Mayo Clinic. By the time the patient reached there, the clinical investigation included a battery of testing for causes of anemia—all within normal limits—so a bone marrow examination was performed which revealed a significant, though not acute (<20% blasts), myelodysplastic process. A follow-up in-house bone marrow collection revealed hypercellular marrow, now in acute myeloid proliferation, with abnormal myeloid cell maturation and very complex cytogenetics. She had a very complex karyotype and several detectable mutations which were consistent with the WHO’s classification and description of therapy-related myeloid neoplasm as a sequale to the treatments she received for her prior cancers. In the setting of a patient with LFS, it is almost impossible to avoid malignancy. The following slides are a (very abridged) summary taken from my presentation of this patient’s case:













Why All of This Matters
There are two main reasons why all of this is important enough to discuss in a case conference. First, as clinicians from the bench to the bedside we should all strive to talk through the toughest diagnoses and share with each other what best practices, lessons, and goals we can reach together. In the setting of Li-Fraumeni Syndrome it becomes critical to evaluate new onset (especially myeloid) neoplasms. TP53 mutations are associated with the lowest survival rates in acute myeloid leukemia, which has its own diagnostic and prognostic classifications set forth by the World Health Organization. Furthermore, understanding appropriate patient history, clinical information, and what appropriate lab investigation means is crucial. It not only keeps the needs and interests of the patient first, but also translates to the proper utilization of resources for the best results in the best timelines. Potential future implications of concurrent ongoing work in hematopathology and molecular genetics may yield therapeutic and diagnostic benefits we are not yet aware of—we must constantly include updates as we practice.
Second, this was an opportunity to share insights into the diagnosis and discussion of AML that came from my clinical experiences before rotating there. I previously mentioned the demonstrated value of including clinical viewpoints for the benefit of patient care outcomes, so appropriately I incorporated these topics into this case conference and included the following points to consider:
- Hematologic premetastatic niches
When I was in graduate school at Rush University in Chicago, I did some research in hematopoietic responses to various therapies in the context of proliferation and understanding mobilization for transplant and engraftment. In this work, I became familiar with the concept of a reactive stroma and a “pre-metastatic niche.” There are small microenvironments in which hematopoietic, mesenchymal, and endothelial cell lines in the bone marrow thrive and develop which are full of cytokines and cell-cell interactions. My work focused on mobilizing all three lines with a CXCR4 target, but the concept holds true when considering germline and somatic mutability. In effect, those cells with pre-malignant mutations can cluster and affect the environment of other cells maturing in the same setting. The same way invasive cells can break through barriers to metastasize and spread past their in situ conditions, the same mobilizing spread can grow from pre-metastatic clusters. This, again, opens the discussion for treatment targets in future LFS and/or AML patients as molecular pathology expands.
- Acute Myeloid Leukemia and Myeloid Sarcoma
In a recently published paper in Histopathology, I was part of a team at the UAB hospital’s department of pathology which discussed their experience with patients diagnosed with myeloid sarcomas (MS). The point was to look for correlations with MS to connect the entity with age, sex, location of tumor, AML status, genetics, etc. Ultimately, what became the highest predictor of disease was a complex karyotype, consistent with other concurrent literature. With respect to this patient, what if there was another soft tissue (or other location) sarcoma alongside her myelodysplastic picture. What if she had a low blast count, or hypocellular bone marrow, or necrosis/fibrosis, or had received G-CSF? Would AML with myeloid sarcoma be considered in this diagnostic setting, would myeloid sarcoma be something to worry about in her future or in her clinical history as a misdiagnosis? The take-home message would be to pay close attention to patient clinical history and stay both focused on the current diagnostic work-up but also open enough to avoid pitfalls in diagnostic challenges.
- Misdiagnosis in clinical settings
In a case report from 2017 I discussed a patient who had bilateral lung nodules several years after being treated for breast carcinoma. It was initially thought to be relapse but was later correctly diagnosed as de novo peripheral T-cell lymphoma (PTCL). This could have very well been the same clinical scenario, with a different cell lineage. The lesson gleaned here is the same as those ASH/CAP guidelines: stay organized, consistent, and purposeful with your testing and investigation. What came down to a few immunohistochemical markers in this PTCL case could make all the difference in another case. Missing the clinical history and specific genetic mutations present in this LFS/AML patient could have led to a diagnosis of a myelodysplasia related AML instead of a therapy-related one, especially in the setting of such a severe germline pre-disposition.
- Future plans for this patient
I thought it was ultimately important to discuss the patient’s future plans with the audience. In pathology we often sign-off after we sign-out. So, in order to make sure we emphasize the patient’s best interests moving forward from a poor prognostic diagnosis, we discussed her enrollment in a trial aimed at improving bone marrow donor matching based on HLA and KIR combination typing. This a relatively new and promising concept in the literature which I hold high hopes for.
If anything, this was something I learned last month: in order for you to call the quality of care the highest possible, you have to uphold many standards, both clinical and non-clinical. Clinically we all have to share with each other the latest and greatest in modern literature and advances in interdisciplinary or translational research. Aside from this, however, we have to keep each other human and connected to our patients. I never like to hear the stereotypes in pathology that place us in lab medicine miles away from patient care; instead, we do things every day that impact our patients’ lives greatly. And when we keep ourselves connected to that fact, like the philosophy at the Mayo Clinic, then we can boast our quality of care—from small community hospital to academic trauma center. Because its not the size of the lens on the scope, it’s the vast scope of impact we look through in a lens of compassion.
There you have it. That’s my month at Mayo and a case conference in a nutshell. It was a fantastic experience and I have to say it—I had a blast!
Thanks for reading, I’ll see you next time!
And have a Happy Lab Week 2019!

–Constantine E. Kanakis MSc, MLS (ASCP)CM graduated from Loyola University Chicago with a BS in Molecular Biology and Bioethics and then Rush University with an MS in Medical Laboratory Science. He is currently a medical student actively involved in public health and laboratory medicine, conducting clinicals at Bronx-Care Hospital Center in New York City.